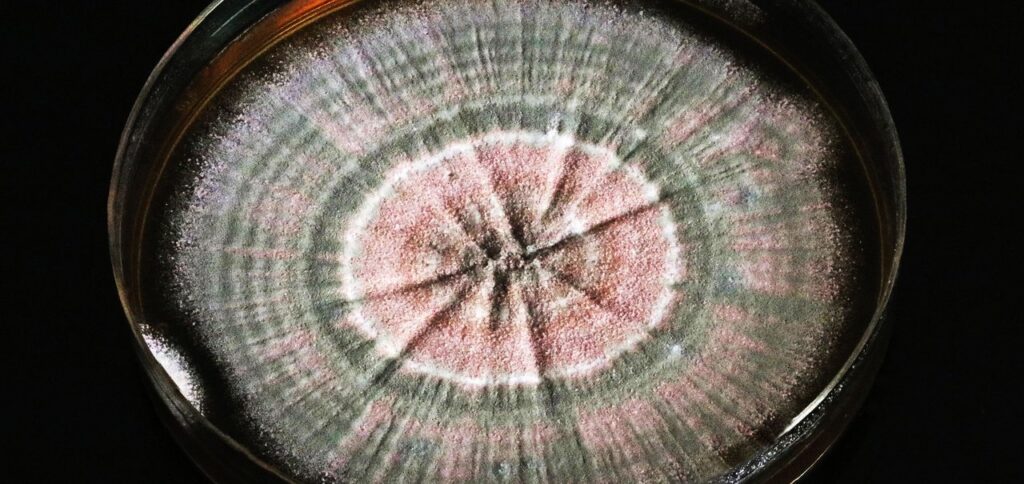

Como algo tão pequeno pode provocar um impacto global? Estamos acostumados com doenças causadas por vírus e bactérias, que em seu tamanho microscópico, se alastram e destroem sistemas orgânicos, contudo, algo um pouco diferente e não diretamente patogênico tem causado impacto semelhante na destruição do sistema ambiental: microplásticos.
O descarte incorreto dos diferentes tipos de polímeros plásticos ocasionou na formação do que conhecemos agora por microplástico. A ação dos agentes físicos e climáticos foram aos poucos quebrando esses polímeros, os tornando pequenas peças diminutas de contaminação que, agora, parecem poder ser potencializadores para linhagens mais fortes e resistentes de bactérias.
Entenda um pouco mais sobre os microplásticos e como eles podem causar danos ao meio ambiente e para a saúde humana.

A invasão dos microplásticos
Os microplásticos não são um problema tão recente na história da humanidade. A primeira detecção dessas peças minúsculas datam de meados de 1970 e a sua maior concentração está nos oceanos.
Mas ainda que seja uma ameaça conhecida há 50 anos, seu potencial destruidor tem sido melhor compreendido atualmente, graças a extensos estudos de impacto na saúde ambiental e humana.
Ainda que haja uma quantidade significativa de microplásticos no solo, é sempre interessante recordar que tudo que o que está na terra tem potencial para escoar durante os ciclos de chuva, jogando esses contaminantes nas redes de esgoto que depois tratados, ou não, desembocam em rios e tem seu destino nos oceanos.

Com um tempo estimado de degradação em 400 anos a 500 anos, dependo do polímero, há tempo suficiente para causar grandes impactos no meio ambiente e a contaminação, inclusive, em organismos vivos.
Dentre os principais problemas da presença do microplástico no meio ambiente, podemos destacar: liberação de substâncias tóxicas, desequilíbrio do sistema aquático com a morte de animais, estímulo à proliferação de algas e toda uma cadeia de vida em risco.
Mas o problema não está apenas nos oceanos. Estudos recentes detectaram a presença de microplástico em seres humanos. No leite materno, no sangue, nos pulmões, no estômago e até no cérebro. Acredita-se que eles possam gerar uma grande influência em processos patológicos, contribuindo para o desenvolvimento de doenças cardiovasculares.
Esse tipo de comorbidade não atinge apenas o coração, mas pode gerar tromboses, flebite, que é um tipo de inflamação nas paredes vasculares, acidente vascular cerebral e também parece ser um fator contributivo para o desenvolvimento de doenças neurodegenerativas como o Alzheimer.
E novidades vem por aí com parcerias estrondosas. Esse problema crescente a cada vez mais urgente parece estar atuando em colaboração com outro problema de repercussões muito sérias para a saúde humana. Microplástico e superbactérias podem começar uma colaboração.

Melhores amigos: microplásticos e superbactérias
O ditado “o que não te mata, fortalece” é o mantra das bactérias. Graças ao uso indiscriminado de antibióticos, certas cepas de bactérias foram se tornando cada vez mais fortes e resistentes, gerando um problema imenso de saúde pública.
Ainda que elas estejam mais presentes em ambientes hospitalares, um novo estudo sugere que os microplásticos podem gerar um efeito potencializador para bactérias, como a E. Coli estudada na pesquisa, se fortaleçam e menos sensíveis à terapia medicamentosa.
Isso seria possível porque no meio ambiente, além dos microplásticos também há presença de traços de medicações antibióticas descartadas de maneira incorreta. Então temos a união da tríade do apocalipse: bactérias, microplásticos e medicações descartadas incorretamente.

O estudo revela que a superfície do microplástico é muito propensa à formação de biofilmes que contribuem para a adesão de moléculas dispersas das medicações e o crescimento das bactérias.
Como a molécula do medicamento não tem força suficiente para matar a bactéria, ele pode provocar nela algumas mutações que podem tornar as novas gerações resistentes.
Esses microrganismos também estão sujeitos aos processos de seleção natural, por isso você toma a medicação por sete dias ou mais, para ter certeza de que todas as bactérias patogênicas estejam mortas. Quando você faz o uso incorreto, pode ser que as mais resistentes sobrevivam, provocando infecções refratárias difíceis de manejar.
O microplástico então funciona como um ponto de encontro, um lugarzinho quente e aconchegante para a seleção natural e problemas sérios para a saúde humana e do meio ambiente, pois se antes as bactérias resistentes eram mais propensas a ser encontradas apenas em hospitais e serviços de saúde, agora elas podem se desenvolver em alto mar e outras áreas com excesso de microplásticos.

Outros estudos devem se aprofundar nessa relação de berçários microscópicos e os impactos na saúde humana e do meio ambiente. Mas até que se possa ter uma dimensão mais real dos desdobramentos dessas relações, você pode contribuir sendo um cidadão consciente.
Descarte o lixo em locais adequados, de preferência separando o lixo orgânico e o reciclável. Caso não tenha uma lixeira por perto, reserve no bolso da calça ou em um bolsinho da mochila para descartar depois.
Em relação às medicações, sempre faça o uso pelo tempo previsto no receituário, e caso sobre medicação, descarte nos pontos de coleta presentes em farmácias ou unidades de saúde. Nada de dar descarga ou jogar no ralo. Com pequenas ações podemos contribuir para impactos menores em nossa comunidade e no meio ambiente.
E você sabia que o microplástico poderia dar toda essa dor de cabeça? Agora, a aparente união de forças pode resultar em problemas ainda mais severos. E se você ficou interessado e quer saber um pouco mais, veja até onde essas minúsculas partículas foram detectadas. Continue acompanhando o TecMundo e descarte corretamente o lixo e as medicações. Vida longa e próspera. Até breve.
Fonte.: TecMundo